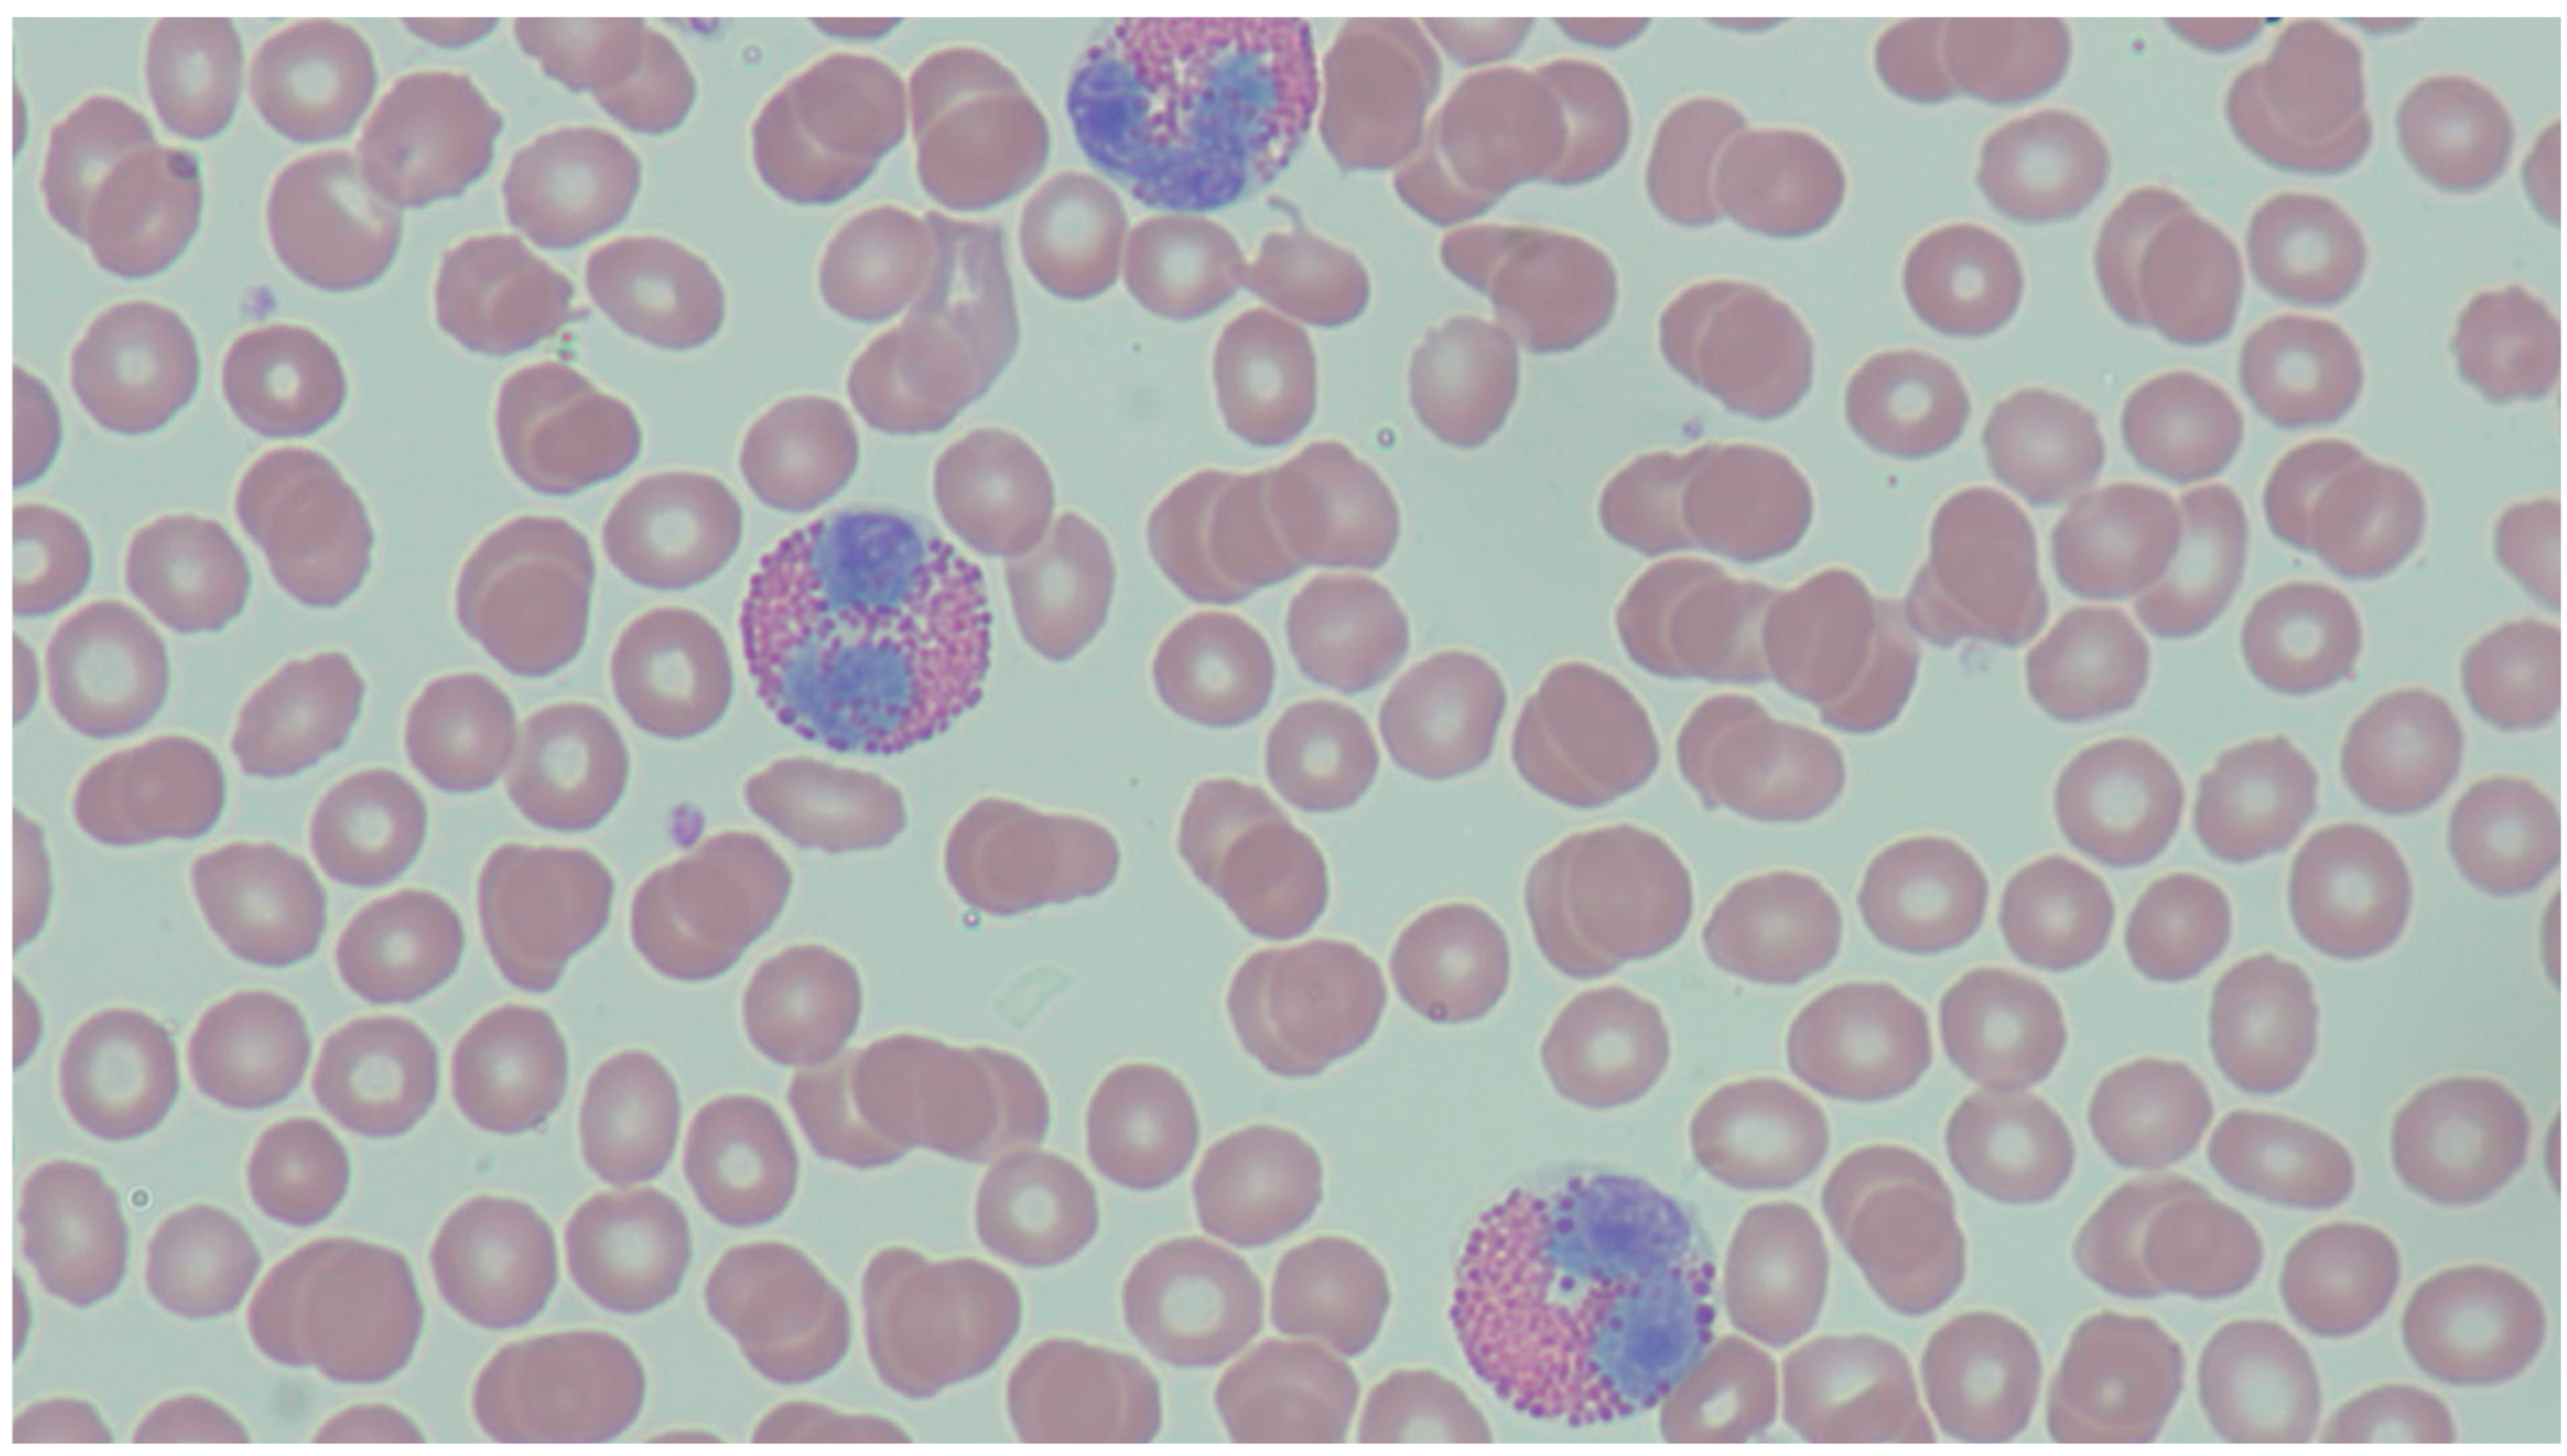
Hemato 05 00008 g001 Hemato 05 00008 g001

Review of Peripheral Blood Eosinophilia: Workup and Differential Diagnosis
Abstract
1. Introduction
2. Cutaneous Processes
2.1. Atopic Dermatitis
2.2. Contact Dermatitis
2.3. Cutaneous T-Cell Lymphomas
2.4. Eosinophilic Cellulitis/Dermatitis (Wells’ Syndrome)
2.5. Episodic Angioedema with Eosinophilia (Gleich’s Syndrome)
2.6. Bullous Pemphigoid
2.7. Pemphigus
2.8. Eosinophilic Pustular Folliculitis
2.9. Systemic Sclerosis
3. Respiratory Processes
4. Upper Respiratory Processes
4.1. Allergic Rhinitis
4.2. Chronic Sinusitis
4.3. Nasal Polyps
5. Lower Respiratory Processes
5.1. Aspirin-Exacerbated Respiratory Disease
5.2. Asthma
5.3. Allergic Bronchopulmonary Aspergillosis
5.4. Eosinophilic Pneumonia
5.5. Drug-Induced Eosinophilic Lung Disease
5.6. Chronic Obstructive Pulmonary Disease
5.7. Lung Transplantation
6. Cardiovascular Processes
6.1. Eosinophilic Myocarditis
6.2. Cholesterol Crystal Embolism
7. Gastrointestinal Processes
7.1. Eosinophilic Esophagitis, Gastritis, and Colitis
7.2. Eosinophilic Pancreatitis
8. Endocrine Processes
8.1. Adrenal Insufficiency
8.2. Hypopituitarism
9. Rheumatologic and Musculoskeletal Processes
10. Infectious Processes
11. Neoplastic Processes
11.1. Chronic Myeloid Leukemia
11.2. Langerhans Cell Histiocytosis
11.3. Mastocytosis
11.4. Solid Tumor
12. Allergic and Immunologic Processes
12.1. Idiopathic Hypereosinophilic Syndrome
12.2. Hyper IgE Syndrome (Job Syndrome)
12.3. Drug-Induced Eosinophilia
12.4. Drug-Induced Hypersensitivity Syndrome
12.5. Omenn Syndrome
13. Other Processes
Radiation Exposure
14. Framework for Evaluation of Peripheral Eosinophilia
15. Conclusions
Author Contributions
Funding
Acknowledgments
Conflicts of Interest
References
- Chapman, J.; Zhang, Y. Histology, Hematopoiesis; StatPearls Publishing: Treasure Island, FL, USA, 2023. [Google Scholar]
- Kanuru, S.; Sapra, A. Eosinophilia; StatPearls Publishing: Treasure Island, FL, USA, 2023. [Google Scholar]
- Park, Y.M.; Bochner, B.S. Eosinophil survival and apoptosis in health and disease. Allergy Asthma Immunol. Res. 2010, 2, 87–101. [Google Scholar] [CrossRef]
- Garg, G.; Gogia, A.; Kakar, A.; Miglani, P. Persistent Marked Peripheral Eosinophilia due to Tuberculosis: A Case Report. Iran. J. Med. Sci. 2017, 42, 102–105. [Google Scholar]
- Radonjic-Hoesli, S.; Brüggen, M.C.; Feldmeyer, L.; Simon, H.U.; Simon, D. Eosinophils in skin diseases. Semin. Immunopathol. 2021, 43, 393–409. [Google Scholar]
- Chu, D.K.; Schneider, L.; Asiniwasis, R.N.; Boguniewicz, M.; De Benedetto, A.; Ellison, K.; Frazier, W.T.; Greenhawt, M.; Huynh, J.; Kim, E.; et al. Atopic dermatitis (eczema) guidelines: 2023 American Academy of Allergy, Asthma and Immunology/American College of Allergy, Asthma and Immunology Joint Task Force on Practice Parameters GRADE– and Institute of Medicine–based recommendations. Ann. Allergy Asthma Immunol. 2023, 132, 274–312. [Google Scholar] [CrossRef]
- Leiferman, K.M. Eosinophils in atopic dermatitis. J. Allergy Clin. Immunol. 1994, 94 Pt 2, 1310–1317. [Google Scholar] [CrossRef]
- Simon, D.; Braathen, L.R.; Simon, H.U. Eosinophils and atopic dermatitis. Allergy 2004, 59, 561–570. [Google Scholar] [CrossRef]
- Celakovska, J.; Bukac, J.; Ettler, K.; Vaneckova, J.; Krcmova, I.; Ettlerova, K.; Krejsek, J. Evaluation of Peripheral Blood Eosinophilia in Adolescent and Adult Patients Suffering from Atopic Dermatitis and the Relation to the Occurrence of Allergy to Aeroallergens. Indian. J. Dermatol. 2019, 64, 34–40. [Google Scholar] [CrossRef]
- Adler, B.L.; DeLeo, V.A. Allergic Contact Dermatitis. JAMA Dermatol. 2021, 157, 364. [Google Scholar] [CrossRef]
- Haussmann, J.; Pratt, M.; Linett, L.; Zimmerman, D. Allergic contact dermatitis and eosinophilia in association with a hemodialysis cannula. Am. J. Kidney Dis. 2005, 45, e23–e26. [Google Scholar] [CrossRef]
- Lloréns Herrerias, J.; Delgado Navarro, C.; Ballester Luján, M.T.; Izquierdo Palomares, A. Long-term allergic dermatitis caused by sevoflurane: A clinical report. Acta Anaesthesiol. Scand. 2014, 58, 1151–1153. [Google Scholar] [CrossRef]
- Castellanos-González, M.; Velasco Rodriguez, D.; Blanco Echevarría, A.; Postigo, C.; Ortiz Romero, P.; Díaz, R.A.; Rodriguez-Peralto, J.L. Eosinophilic fasciitis as a manifestation of a cutaneous T-cell lymphoma not otherwise specified. Am. J. Dermatopathol. 2013, 35, 666–670. [Google Scholar] [CrossRef]
- Nielsen, M.; Nissen, M.H.; Gerwien, J.; Zocca, M.B.; Rasmussen, H.M.; Nakajima, K.; Röpke, C.; Geisler, C.; Kaltoft, K.; Ødum, N. Spontaneous interleukin-5 production in cutaneous T-cell lymphoma lines is mediated by constitutively activated Stat3. Blood 2002, 99, 973–977. [Google Scholar] [CrossRef]
- Borish, L.; Dishuck, J.; Cox, L.; Mascali, J.J.; Williams, J.; Rosenwasser, L.J. Sézary syndrome with elevated serum IgE and hypereosinophilia: Role of dysregulated cytokine production. J. Allergy Clin. Immunol. 1993, 92 Pt 1, 123–131. [Google Scholar] [CrossRef]
- Sinno, H.; Lacroix, J.P.; Lee, J.; Izadpanah, A.; Borsuk, R.; Watters, K.; Gilardino, M. Diagnosis and management of eosinophilic cellulitis (Wells’ syndrome): A case series and literature review. Can. J. Plast. Surg. 2012, 20, 91–97. [Google Scholar] [CrossRef]
- Khoury, P.; Herold, J.; Alpaugh, A.; Dinerman, E.; Holland-Thomas, N.; Stoddard, J.; Gurprasad, S.; Maric, I.; Simakova, O.; Schwartz, L.B.; et al. Episodic angioedema with eosinophilia (Gleich syndrome) is a multilineage cell cycling disorder. Haematologica. 2015, 100, 300–307. [Google Scholar] [CrossRef]
- O’Sullivan, J.A.; Bochner, B.S. Eosinophils and eosinophil-associated diseases: An update. J. Allergy Clin. Immunol. 2018, 141, 505–517. [Google Scholar] [CrossRef]
- Messingham, K.N.; Crowe, T.P.; Fairley, J.A. The Intersection of IgE Autoantibodies and Eosinophilia in the Pathogenesis of Bullous Pemphigoid. Front. Immunol. 2019, 10, 2331. [Google Scholar]
- Kridin, K. Peripheral eosinophilia in bullous pemphigoid: Prevalence and influence on the clinical manifestation. Br. J. Dermatol. 2018, 179, 1141–1147. [Google Scholar] [CrossRef]
- Zaraa, I.; Sellami, A.; Bouguerra, C.; Sellami, M.; Chelly, I.; Zitouna, M.; Makni, S.; Hmida, A.; Mokni, M.; Osman, A. Pemphigus vegetans: A clinical, histological, immunopathological and prognostic study. J. Eur. Acad. Dermatol. Venereol. 2011, 25, 1160–1167. [Google Scholar] [CrossRef]
- Laws, P.M.; Heelan, K.; Al-Mohammedi, F.; Walsh, S.; Shear, N.H. Pemphigus herpetiformis: A case series and review of the literature. Int. J. Dermatol. 2015, 54, 1014–1022. [Google Scholar] [CrossRef]
- Curto-Barredo, L.; Segura, S.; Ishii, N.; Hashimoto, T.; Mascaró, J.M., Jr.; Espinet, B.; Besses, C.; Pujol, R.M. Pemphigus-like hypereosinophilic syndrome with FIP1L1-PDGFRA fusion gene: A challenging and uncommon clinical presentation. J. Dermatol. 2019, 46, 531–534. [Google Scholar] [CrossRef]
- Sufyan, W.; Tan, K.B.; Wong, S.T.; Lee, Y.S. Eosinophilic pustular folliculitis. Arch. Pathol. Lab. Med. 2007, 131, 1598–1601. [Google Scholar] [CrossRef]
- Foocharoen, C.; Mahakkanukrauh, A.; Maleewong, P.; Maleewong, W.; Jumnainsong, A.; Pongkulkiat, P.; Teawtrakul, N.; Suwannaroj, S.; Nanagara, R. Prevalence of peripheral eosinophilia and clinical associations in systemic sclerosis patients. Am. J. Med. Sci. 2022, 363, 519–525. [Google Scholar] [CrossRef]
- Punjasamanvong, S.; Muangchan, C. Persistent eosinophilia and associated organ involvement in Thai patients with systemic sclerosis: Data from the Siriraj scleroderma cohort. Arch. Rheumatol. 2021, 36, 527–537. [Google Scholar] [CrossRef]
- Hara, T.; Ikeda, T.; Inaba, Y.; Kunimoto, K.; Mikita, N.; Kaminaka, C.; Kanazawa, N.; Yamamoto, Y.; Tabata, K.; Fujii, T.; et al. Peripheral blood eosinophilia is associated with the presence of skin ulcers in patients with systemic sclerosis. J. Dermatol. 2019, 46, 334–337. [Google Scholar] [CrossRef]
- Howarth, P.H. Eosinophils and rhinitis. Clin. Exp. Allergy Rev. 2005, 5, 55–63. [Google Scholar] [CrossRef]
- Newman, L.J.; Platts-Mills, T.A.E.; Douglas Phillips, C.; Hazen, K.C.; Gross, C.W. Chronic Sinusitis: Relationship of Computed Tomographic Findings to Allergy, Asthma, and Eosinophilia. JAMA 1994, 271, 363–367. [Google Scholar] [CrossRef]
- Bhattacharyya, N.; Fried, M.P. Peripheral eosinophilia in the diagnosis of chronic rhinosinusitis. Am. J. Otolaryngol. 2001, 22, 116–120. [Google Scholar] [CrossRef]
- Laidlaw, T.M.; Mullol, J.; Woessner, K.M.; Amin, N.; Mannent, L.P. Chronic Rhinosinusitis with Nasal Polyps and Asthma. J. Allergy Clin. Immunol. Pract. 2021, 9, 1133–1141. [Google Scholar] [CrossRef]
- Gevaert, P.; Han, J.K.; Smith, S.G.; Sousa, A.R.; Howarth, P.H.; Yancey, S.W.; Chan, R.; Bachert, C. The roles of eosinophils and interleukin-5 in the pathophysiology of chronic rhinosinusitis with nasal polyps. Int. Forum Allergy Rhinol. 2022, 12, 1413–1423. [Google Scholar] [CrossRef]
- Weissler, J.C. Eosinophilic Lung Disease. Am. J. Med. Sci. 2017, 354, 339–349. [Google Scholar] [CrossRef]
- De Giacomi, F.; Vassallo, R.; Yi, E.S.; Ryu, J.H. Acute Eosinophilic Pneumonia. Causes, Diagnosis, and Management. Am. J. Respir. Crit. Care Med. 2018, 197, 728–736. [Google Scholar] [CrossRef]
- Haque, R.; White, A.A.; Jackson, D.J.; Hopkins, C. Clinical evaluation and diagnosis of aspirin-exacerbated respiratory disease. J. Allergy Clin. Immunol. 2021, 148, 283–291. [Google Scholar] [CrossRef]
- Hsia, J.; Sarin, N.; Oliver, J.H.; Goldstein, A.L. Aspirin and thymosin increase interleukin-2 and interferon-gamma production by human peripheral blood lymphocytes. Immunopharmacology 1989, 17, 167–173. [Google Scholar] [CrossRef] [PubMed]
- Steinke, J.W.; Negri, J.; Liu, L.; Payne, S.C.; Borish, L. Aspirin activation of eosinophils and mast cells: Implications in the pathogenesis of aspirin-exacerbated respiratory disease. J. Immunol. 2014, 193, 41–47. [Google Scholar] [CrossRef] [PubMed]
- Walford, H.H.; Doherty, T.A. Diagnosis and management of eosinophilic asthma: A US perspective. J. Asthma Allergy 2014, 7, 53–65. [Google Scholar] [PubMed]
- Tabèze, L.; Marchand-Adam, S.; Borie, R.; Justet, A.; Dupin, C.; Dombret, M.-C.; Crestani, B.; Taillé, C. Severe asthma with blood hypereosinophilia associated with JAK2 V617F mutation: A case series. Eur. Respir. J. 2019, 53, 1802248. [Google Scholar] [CrossRef] [PubMed]
- Sisodia, J.; Bajaj, T. Allergic Bronchopulmonary Aspergillosis; StatPearls Publishing: Treasure Island, FL, USA, 2023. [Google Scholar]
- Rhee, C.K.; Min, K.H.; Yim, N.Y.; Lee, J.E.; Lee, N.R.; Chung, M.P.; Jeon, K. Clinical characteristics and corticosteroid treatment of acute eosinophilic pneumonia. Eur. Respir. J. 2013, 41, 402–409. [Google Scholar] [CrossRef] [PubMed]
- Bafadhel, M.; McKenna, S.; Terry, S.; Mistry, V.; Reid, C.; Haldar, P.; McCormick, M.; Haldar, K.; Kebadze, T.; Duvoix, A.; et al. Acute exacerbations of chronic obstructive pulmonary disease: Identification of biologic clusters and their biomarkers. Am. J. Respir. Crit. Care Med. 2011, 184, 662–671. [Google Scholar] [CrossRef] [PubMed]
- Singh, D. Blood Eosinophil Counts in Chronic Obstructive Pulmonary Disease: A Biomarker of Inhaled Corticosteroid Effects. Tuberc. Respir. Dis. 2020, 83, 185–194. [Google Scholar] [CrossRef]
- Kolsum, U.; Ravi, A.; Hitchen, P.; Maddi, S.; Southworth, T.; Singh, D. Clinical characteristics of eosinophilic COPD versus COPD patients with a history of asthma. Respir. Res. 2017, 18, 73. [Google Scholar] [CrossRef] [PubMed]
- Siddiqui, S.H.; Guasconi, A.; Vestbo, J.; Jones, P.; Agusti, A.; Paggiaro, P.; Wedzicha, J.A.; Singh, D. Blood Eosinophils: A Biomarker of Response to Extrafine Beclomethasone/Formoterol in Chronic Obstructive Pulmonary Disease. Am. J. Respir. Crit. Care Med. 2015, 192, 523–525. [Google Scholar] [CrossRef]
- Tashkin, D.P.; Wechsler, M.E. Role of eosinophils in airway inflammation of chronic obstructive pulmonary disease. Int. J. Chronic Obstr. Pulm. Dis. 2018, 13, 335–349. [Google Scholar] [CrossRef] [PubMed]
- Verleden, S.E.; Ruttens, D.; Vandermeulen, E.; van Raemdonck, D.E.; Vanaudenaerde, B.M.; Verleden, G.M.; Vos, R. Elevated bronchoalveolar lavage eosinophilia correlates with poor outcome after lung transplantation. Transplantation 2014, 97, 83–89. [Google Scholar] [CrossRef] [PubMed]
- Verleden, S.E.; Ruttens, D.; Vandermeulen, E.; Bellon, H.; Dubbeldam, A.; De Wever, W.; Dupont, L.J.; Van Raemdonck, D.E.; Vanaudenaerde, B.M.; Verleden, G.M.; et al. Predictors of survival in restrictive chronic lung allograft dysfunction after lung transplantation. J. Hear. Lung Transplant. 2016, 35, 1078–1084. [Google Scholar] [CrossRef] [PubMed]
- Brambatti, M.; Matassini, M.V.; Adler, E.D.; Klingel, K.; Camici, P.G.; Ammirati, E. Eosinophilic Myocarditis: Characteristics, Treatment, and Outcomes. J. Am. Coll. Cardiol. 2017, 70, 2363–2375. [Google Scholar] [CrossRef]
- Sheikh, H.; Siddiqui, M.; Uddin, S.M.M.; Haq, A.; Yaqoob, U. The Clinicopathological Profile of Eosinophilic Myocarditis. Cureus 2018, 10, e3677. [Google Scholar] [CrossRef]
- Techasatian, W.; Gozun, M.; Vo, K.; Yokoyama, J.; Nagamine, T.; Shah, P.; Vu, K.; Zhang, J.; Nishimura, Y. Eosinophilic myocarditis: Systematic review. Heart 2023. [CrossRef]
- Buchanan, C.E.; Kakkar, E.; Dreskin, S.C.; Allen, L.A.; Groves, D.W.; Altman, N.L. Allergy and the Heart: Eosinophilic Myocarditis with Biventricular Thrombi. JACC Case Rep. 2020, 2, 1942–1946. [Google Scholar] [CrossRef]
- Mochida, Y.; Ohtake, T.; Ishioka, K.; Oka, M.; Maesato, K.; Moriya, H.; Hidaka, S.; Kobayashi, S. Association between eosinophilia and renal prognosis in patients with pathologically proven cholesterol crystal embolism. Clin. Exp. Nephrol. 2020, 24, 680–687. [Google Scholar] [CrossRef]
- Kasinath, B.S.; Lewis, E.J. Eosinophilia as a clue to the diagnosis of atheroembolic renal disease. Arch. Intern. Med. 1987, 147, 1384–1385. [Google Scholar] [CrossRef]
- Cecioni, I.; Fassio, F.; Gori, S.; Giudizi, M.G.; Romagnani, S.; Almerigogna, F. Eosinophilia in cholesterol atheroembolic disease. J. Allergy Clin. Immunol. 2007, 120, 1470–1471. [Google Scholar] [CrossRef]
- Lwin, T.; Melton, S.D.; Genta, R.M. Eosinophilic gastritis: Histopathological characterization and quantification of the normal gastric eosinophil content. Mod. Pathol. 2011, 24, 556–563. [Google Scholar] [CrossRef]
- Brenner, E.J.; Greenberg, S.B.; Chang, N.C.; Corder, S.R.; Cowherd, E.L.; Dellon, E.S. Peripheral eosinophilia and hypoalbuminemia are associated with a higher biopsy diagnostic yield for eosinophilic gastroenteritis. Clin. Res. Hepatol. Gastroenterol. 2021, 45, 101746. [Google Scholar] [CrossRef]
- Chen, P.H.; Anderson, L.; Zhang, K.; Weiss, G.A. Eosinophilic Gastritis/Gastroenteritis. Curr. Gastroenterol. Rep. 2021, 23, 13. [Google Scholar] [CrossRef]
- Zhang, M.; Li, Y. Eosinophilic gastroenteritis: A state-of-the-art review. J. Gastroenterol. Hepatol. 2017, 32, 64–72. [Google Scholar] [CrossRef]
- Kinoshita, Y.; Furuta, K.; Ishimaura, N.; Ishihara, S.; Sato, S.; Maruyama, R.; Ohara, S.; Matsumoto, T.; Sakamoto, C.; Matsui, T.; et al. Clinical characteristics of Japanese patients with eosinophilic esophagitis and eosinophilic gastroenteritis. J. Gastroenterol. 2013, 48, 333–339. [Google Scholar] [CrossRef]
- Kuss, H.J.; Jungkunz, G. Nonlinear pharmacokinetics of chlorimipramine after infusion and oral administration in patients. Prog. Neuro-Psychopharmacol. Biol. Psychiatry 1986, 10, 739–748. [Google Scholar] [CrossRef] [PubMed]
- Lehman, H.K.; Lam, W. Eosinophilic Esophagitis. Pediatr. Clin. N. Am. 2019, 66, 955–965. [Google Scholar] [CrossRef]
- Ruffner, M.A.; Shoda, T.; Lal, M.; Mrozek, Z.; Muir, A.B.; Spergel, J.M.; Dellon, E.S.; Rothenberg, M.E. Persistent Esophageal Changes Following Histologic Remission in Eosinophilic Esophagitis. J. Allergy Clin. Immunol. 2023. [CrossRef]
- Muftah, M.; Barshop, K.; Redd, W.D.; Goldin, A.H.; Lo, W.K.; Chan, W.W. Baseline Peripheral Eosinophil Count Independently Predicts Proton Pump Inhibitor Response in Eosinophilic Esophagitis. J. Clin. Gastroenterol. 2023, 58, 242–246. [Google Scholar] [CrossRef]
- Kaurrany, M.R.; Akil, M.A.; Punagi, A.Q.; Parewangi, A.M.L. Clinical profile and characteristics of eosinophilic esophagitis patients presenting with refractory gastroesophageal reflux disease in Makassar, Indonesia. Pan. Afr. Med. J. 2022, 41, 93. [Google Scholar] [CrossRef]
- Okpara, N.; Aswad, B.; Baffy, G. Eosinophilic colitis. World J. Gastroenterol. 2009, 15, 2975–2979. [Google Scholar] [CrossRef]
- Alfadda, A.A.; Storr, M.A.; Shaffer, E.A. Eosinophilic colitis: Epidemiology, clinical features, and current management. Therap Adv. Gastroenterol. 2011, 4, 301–309. [Google Scholar] [CrossRef]
- Haasnoot, M.L.; Mookhoek, A.; Duijvestein, M.; D’Haens, G.R.A.M.; Bredenoord, A.J. Prognostic Value of Colonic Tissue and Blood Eosinophils in Ulcerative Colitis. Inflamm. Bowel Dis. 2023, 29, 62–69. [Google Scholar] [CrossRef]
- Manohar, M.; Kandikattu, H.K.; Upparahalli Venkateshaiah, S.; Yadavalli, C.S.; Mishra, A. Eosinophils in the pathogenesis of pancreatic disorders. Semin. Immunopathol. 2021, 43, 411–422. [Google Scholar] [CrossRef]
- Tian, L.; Fu, P.; Dong, X.; Qi, J.; Zhu, H. Eosinophilic pancreatitis: Three case reports and literature review. Mol. Clin. Oncol. 2016, 4, 559–562. [Google Scholar] [CrossRef]
- Sun, Y.; Pan, D.; Kang, K.; Sun, M.-J.; Li, Y.-L.; Sang, L.-X.; Chang, B. Eosinophilic pancreatitis: A review of the pathophysiology, diagnosis, and treatment. Gastroenterol. Rep. 2021, 9, 115–124. [Google Scholar] [CrossRef] [PubMed]
- Kandikattu, H.K.; Manohar, M.; Verma, A.K.; Kumar, S.; Yadavalli, C.S.; Venkateshaiah, S.U.; Mishra, A. Macrophages-induced IL-18-mediated eosinophilia promotes characteristics of pancreatic malignancy. Life Sci. Alliance 2021, 4, e202000979. [Google Scholar] [CrossRef]
- Manohar, M.; Verma, A.K.; Venkateshaiah, S.U.; Mishra, A. Role of eosinophils in the initiation and progression of pancreatitis pathogenesis. Am. J. Physiol. Gastrointest. Liver Physiol. 2018, 314, G211–G222. [Google Scholar] [CrossRef]
- Agawa, S.; Futagami, S.; Yamawaki, H.; Tsushima, R.; Higuchi, K.; Habiro, M.; Kawawa, R.; Kodaka, Y.; Ueki, N.; Watanabe, Y.; et al. Trypsin may be associated with duodenal eosinophils through the expression of PAR2 in early chronic pancreatitis and functional dyspepsia with pancreatic enzyme abnormalities. PLoS ONE 2022, 17, e0275341. [Google Scholar] [CrossRef]
- Tokoo, M.; Oguchi, H.; Kawa, S.; Homma, T.; Nagata, A. Eosinophilia associated with chronic pancreatitis: An analysis of 122 patients with definite chronic pancreatitis. Am. J. Gastroenterol. 1992, 87, 455–460. [Google Scholar]
- Wang, Q.; Lu, C.M.; Guo, T.; Qian, J.M. Eosinophilia associated with chronic pancreatitis. Pancreas 2009, 38, 149–153. [Google Scholar] [CrossRef]
- Huecker, M.R.; Bhutta, B.S.; Dominique, E. Adrenal Insufficiency; StatPearls Publishing: Treasure Island, FL, USA, 2023. [Google Scholar]
- Spry, C. Eosinophilia in Addison’s disease. Yale J. Biol. Med. 1976, 49, 411–413. [Google Scholar]
- Boyer, M.H.; Basten, A.; Beeson, P.B. Mechanism of Eosinophilia. III. Suppression of Eosinophilia by Agents Known to Modify Immune Responses. Blood 1970, 36, 458–469. [Google Scholar] [CrossRef]
- Furuichi, N.; Naganuma, A.; Kaburagi, T.; Suzuki, Y.; Hoshino, T.; Shibusawa, N.; Horiguchi, S.; Hatanaka, T.; Kakizaki, S.; Uraoka, T. Three cases of immune-related hypopituitarism after atezolizumab-bevacizumab treatment for hepatocellular carcinoma. Clin. J. Gastroenterol. 2023, 16, 422–431. [Google Scholar] [CrossRef]
- Hsu, C.C.; Lin, H.D.; Huang, C.Y.; Chiang, Y.L. Unusual manifestations of adrenal insufficiency: A case report of hypopituitarism and Well’s syndrome after apoplexy of a silent pituitary gonadotropic adenoma. Medicine 2022, 101, e29274. [Google Scholar] [CrossRef]
- Ratarasarn, C.; Rajatanavin, R.; Himathongkam, T. Salient clinical features of Sheehan’s syndrome. J. Med. Assoc. Thai. 1989, 72, 41–47. [Google Scholar] [PubMed]
- Tamaki, H.; Chatterjee, S.; Langford, C.A. Eosinophilia in Rheumatologic/Vascular Disorders. Immunol. Allergy Clin. N. Am. 2015, 35, 453–476. [Google Scholar] [CrossRef] [PubMed]
- Cottin, V.; Bel, E.; Bottero, P.; Dalhoff, K.; Humbert, M.; Lazor, R.; Sinico, R.A.; Sivasothy, P.; Wechsler, M.E.; Groh, M.; et al. Revisiting the systemic vasculitis in eosinophilic granulomatosis with polyangiitis (Churg-Strauss): A study of 157 patients by the Groupe d’Etudes et de Recherche sur les Maladies Orphelines Pulmonaires and the European Respiratory Society Taskforce on eosinophilic granulomatosis with polyangiitis (Churg-Strauss). Autoimmun. Rev. 2017, 16, 1–9. [Google Scholar] [PubMed]
- Murag, S.; Melehani, J.; Filsoof, D.; Nadeau, K.; Sharon Chinthrajah, R. Dupilumab unmasks eosinophilic granulomatosis with polyangiitis. Chest 2021, 160, A8–A9. [Google Scholar] [CrossRef]
- Ming, B.; Zhong, J.; Dong, L. Role of eosinophilia in IgG4-related disease. Clin. Exp. Rheumatol. 2022, 40, 1038–1044. [Google Scholar] [CrossRef] [PubMed]
- Culver, E.L.; Sadler, R.; Bateman, A.C.; Makuch, M.; Cargill, T.; Ferry, B.; Aalberse, R.; Barnes, E.; Rispens, T. Increases in IgE, Eosinophils, and Mast Cells Can be Used in Diagnosis and to Predict Relapse of IgG4-Related Disease. Clin. Gastroenterol. Hepatol. 2017, 15, 1444–1452.e6. [Google Scholar] [CrossRef] [PubMed]
- Lakhanpal, S.; Ginsburg, W.W.; Michet, C.J.; Doyle, J.A.; Moore, S.B. Eosinophilic fasciitis: Clinical spectrum and therapeutic response in 52 cases. Semin. Arthritis Rheum. 1988, 17, 221–231. [Google Scholar] [CrossRef] [PubMed]
- Danis, R.; Akbulut, S.; Altintas, A.; Ozmen, S.; Ozmen, C.A. Unusual presentation of eosinophilic fasciitis: Two case reports and a review of the literature. J. Med. Case Rep. 2010, 4, 46. [Google Scholar] [CrossRef] [PubMed]
- Allen, J.A.; Peterson, A.; Sufit, R.; Hinchcliff, M.E.; Mahoney, J.M.; Wood, T.A.; Miller, F.W.; Whitfield, M.L.; Varga, J. Post-epidemic eosinophilia-myalgia syndrome associated with L-tryptophan. Arthritis Rheum. 2011, 63, 3633–3639. [Google Scholar] [CrossRef]
- O’Connell, E.M.; Nutman, T.B. Eosinophilia in Infectious Diseases. Immunol. Allergy Clin. N. Am. 2015, 35, 493–522. [Google Scholar] [CrossRef]
- Butt, N.M.; Lambert, J.; Ali, S.; Beer, P.A.; Cross, N.C.P.; Duncombe, A.; Ewing, J.; Harrison, C.N.; Knapper, S.; McLornan, D.; et al. Guideline for the investigation and management of eosinophilia. Br. J. Haematol. 2017, 176, 553–572. [Google Scholar] [CrossRef]
- Mehrotra, S.; Dhiman, R.K.; Sircar, A.R. Hyper-eosinophilic syndrome with lepromatous leprosy. J. Assoc. Physicians India 1988, 36, 287–288. [Google Scholar]
- Vinod, K.V.; Arun, K.; Dutta, T.K. Dapsone hypersensitivity syndrome: A rare life threatening complication of dapsone therapy. J. Pharmacol. Pharmacother. 2013, 4, 158–160. [Google Scholar] [CrossRef]
- Chou, A.; Serpa, J.A. Eosinophilia in patients infected with human immunodeficiency virus. Curr. HIV/AIDS Rep. 2015, 12, 313–316. [Google Scholar] [CrossRef]
- Vega, F.; Medeiros, L.J.; Bueso-Ramos, C.E.; Arboleda, P.; Miranda, R.N. Hematolymphoid neoplasms associated with rearrangements of PDGFRA, PDGFRB, and FGFR1. Am. J. Clin. Pathol. 2015, 144, 377–392. [Google Scholar] [CrossRef]
- Shi, M.; Rech, K.L.; Otteson, G.E.; Horna, P.; Olteanu, H.; Pardanani, A.; Chen, D.; Jevremovic, D. Prevalence and spectrum of T-cell lymphoproliferative disorders in patients with Hypereosinophilia: A reference laboratory experience. Ann. Diagn. Pathol. 2020, 44, 151412. [Google Scholar] [CrossRef]
- Ferruzzi, V.; Santi, E.; Gurdo, G.; Arcioni, F.; Caniglia, M.; Esposito, S. Acute Lymphoblastic Leukemia with Hypereosinophilia in a Child: Case Report and Literature Review. Int. J. Environ. Res. Public Health 2018, 15, 1169. [Google Scholar] [CrossRef]
- Kalejaiye, O.O.; Amaeshi, L.C.; Banjoko, O.O. Unusual Case of Hypereosinophilia in Hodgkin Lymphoma in a Nigerian Woman. AIM Clin. Cases 2024, 3, e230012. [Google Scholar] [CrossRef]
- Kaur, P.; Khan, W.A. Myeloid/Lymphoid Neoplasms with Eosinophilia and Platelet Derived Growth Factor Receptor Alpha (PDGFRA) Rearrangement. In Leukemia; Li, W., Ed.; Exon Publications: Brisbane, Australia, 2022. [Google Scholar]
- Pozdnyakova, O.; Orazi, A.; Kelemen, K.; King, R.; Reichard, K.K.; Craig, F.E.; Quintanilla-Martinez, L.; Rimsza, L.; George, T.I.; Horny, H.P.; et al. Myeloid/Lymphoid Neoplasms Associated with Eosinophilia and Rearrangements of PDGFRA, PDGFRB, or FGFR1 or with PCM1-JAK2. Am. J. Clin. Pathol. 2021, 155, 160–178. [Google Scholar] [CrossRef] [PubMed]
- Reiter, A.; Gotlib, J. Myeloid neoplasms with eosinophilia. Blood 2017, 129, 704–714. [Google Scholar] [CrossRef] [PubMed]
- Bain, B.J. Myeloid and lymphoid neoplasms with eosinophilia and abnormalities of PDGFRA, PDGFRB or FGFR1. Haematologica 2010, 95, 696–698. [Google Scholar] [CrossRef] [PubMed]
- Shomali, W.; Colucci, P.; George, T.I.; Kiladjian, J.-J.; Langford, C.; Patel, J.L.; Reiter, A.; Vannucchi, A.M.; Gotlib, J. Comprehensive response criteria for myeloid/lymphoid neoplasms with eosinophilia and tyrosine kinase gene fusions: A proposal from the MLN International Working Group. Leukemia 2023, 37, 981–987. [Google Scholar] [CrossRef] [PubMed]
- Zhang, Z.; Zhu, Y.; Wang, Z.; Zeng, Z.; Wen, L.; Zhang, L.; Chen, S. Case Report: A novel FGFR1 fusion in acute B-lymphoblastic leukemia identified by RNA sequencing. Front. Oncol. 2023, 13, 1276695. [Google Scholar] [CrossRef] [PubMed]
- Urrea Pineda, L.Y.; Perilla, O.; Santiago-Pacheco, V.; Trujillo Montoya, S. Myeloproliferative Syndrome With Eosinophilia Associated With Translocation t(8; 13) and T-cell Lymphoblastic Lymphoma: A Case Report and Review of the Literature. Cureus 2022, 14, e22734. [Google Scholar] [CrossRef]
- Wang, Y.; Wu, X.; Deng, J.; Yu, H.; Xu, R.; Zhu, Z.; Tu, S.; Hu, Y. Diagnostic application of next-generation sequencing in ZMYM2-FGFR1 8p11 myeloproliferative syndrome: A case report. Cancer Biol. Ther. 2016, 17, 785–789. [Google Scholar] [CrossRef][Green Version]
- Gerds, A.T.; Gotlib, J.; Bose, P.; Deininger, M.W.; Dunbar, A.; Elshoury, A.; George, T.I.; Gojo, I.; Gundabolu, K.; Hexner, E.; et al. Myeloid/Lymphoid Neoplasms with Eosinophilia and TK Fusion Genes, Version 3.2021, NCCN Clinical Practice Guidelines in Oncology. J. Natl. Compr. Canc Netw. 2020, 18, 1248–1269. [Google Scholar] [CrossRef] [PubMed]
- Mangaru, Z.; Shetty, S.; Visconte, V.; Liu, H.D.; Rogers, H.J. Acute myeloid leukemia with inv(16)(p13.1q22), abnormal eosinophils, and absence of peripheral blood and bone marrow blasts. Am. J. Hematol. 2016, 91, E273–E274. [Google Scholar] [CrossRef] [PubMed]
- Schiffer, C.A.; Stone, R.M. Morphologic Classification and Clinical and Laboratory Correlates; BC Deckerl: Hamilton, ON, USA, 2003. [Google Scholar]
- Bahoush, G.; Vafapour, M.; Kariminejad, R. New translocation in acute myeloid leukemia M4 eos. Leuk. Res. Rep. 2020, 14, 100209. [Google Scholar] [CrossRef] [PubMed]
- Chang, S.T.; Hsieh, Y.C.; Lee, L.P.; Tzeng, C.C.; Chuang, S.S. Acute myelomonocytic leukemia with abnormal eosinophils: A case report with multi-modality diagnostic work-up. Chang. Gung Med. J. 2006, 29, 532–537. [Google Scholar] [PubMed]
- Adriaansen, H.J.; te Boekhorst, P.A.; Hagemeijer, A.M.; van der Schoot, C.E.; Delwel, H.R.; van Dongen, J.J. Acute myeloid leukemia M4 with bone marrow eosinophilia (M4Eo) and inv(16)(p13q22) exhibits a specific immunophenotype with CD2 expression. Blood 1993, 81, 3043–3051. [Google Scholar] [CrossRef] [PubMed]
- Haseyama, Y.; Takeda, Y.; Kumano, K. Chronic myeloid leukemia presenting with marked eosinophilia. Rinsho Ketsueki. 2018, 59, 2594–2599. [Google Scholar] [PubMed]
- Egeler, R.M.; Katewa, S.; Leenen, P.J.M.; Beverley, P.; Collin, M.; Ginhoux, F.; Arceci, R.J.; Rollins, B.J. Langerhans cell histiocytosis is a neoplasm and consequently its recurrence is a relapse: In memory of Bob Arceci. Pediatr. Blood Cancer 2016, 63, 1704–1712. [Google Scholar] [CrossRef] [PubMed]
- Rastogi, N.; Yadav, S.P. Langerhans Cell Histiocytosis Masquerading as Hypereosinophilia in a Child. J. Pediatr. Hematol. Oncol. 2019, 41, 335–336. [Google Scholar] [CrossRef]
- Parambil, A.S.P.; Prem, S.; Jacob, P.M.; Nair, R.A. Mediastinal Mass with Hyper-eosinophilia in a Young Boy -A Diagnostic Dilemma. J. Clin. Diagn. Res. 2016, 10, XD03–XD04. [Google Scholar] [CrossRef] [PubMed]
- Ohnishi, H.; Kandabashi, K.; Maeda, Y.; Kawamura, M.; Watanabe, T. Chronic eosinophilic leukaemia with FIP1L1-PDGFRA fusion and T6741 mutation that evolved from Langerhans cell histiocytosis with eosinophilia after chemotherapy. Br. J. Haematol. 2006, 134, 547–549. [Google Scholar] [CrossRef] [PubMed]
- Ozturk, K.; Cayci, Z.; Gotlib, J.; Akin, C.; George, T.I.; Ustun, C. Non-hematologic diagnosis of systemic mastocytosis: Collaboration of radiology and pathology. Blood Rev. 2021, 45, 100693. [Google Scholar] [CrossRef] [PubMed]
- Böhm, A.; Födinger, M.; Wimazal, F.; Haas, O.A.; Mayerhofer, M.; Sperr, W.R.; Esterbauer, H.; Valent, P. Eosinophilia in systemic mastocytosis: Clinical and molecular correlates and prognostic significance. J. Allergy Clin. Immunol. 2007, 120, 192–199. [Google Scholar] [CrossRef] [PubMed]
- Kluin-Nelemans, H.C.; Reiter, A.; Illerhaus, A.; van Anrooij, B.; Hartmann, K.; Span, L.F.R.; Gorska, A.; Niedoszytko, M.; Lange, M.; Scaffidi, L.; et al. Prognostic impact of eosinophils in mastocytosis: Analysis of 2350 patients collected in the ECNM Registry. Leukemia 2020, 34, 1090–1101. [Google Scholar] [CrossRef] [PubMed]
- Sakane-Ishikawa, E.; Kodaka, T.; Tsunemine, H.; Itoh, K.; Akasaka, H.; Kusama, T.; Imaizumi, K.; Taketomi, M.; Sada, A.; Katayama, Y.; et al. Eosinophilia and bone lesion as clinical manifestations of aggressive systemic mastocytosis. J. Clin. Exp. Hematop. 2013, 53, 207–213. [Google Scholar] [CrossRef] [PubMed][Green Version]
- Zanelli, M.; Ricci, S.; Zizzo, M.; Sanguedolce, F.; De Giorgi, F.; Palicelli, A.; Martino, G.; Ascani, S. Systemic Mastocytosis Associated with “Smoldering” Multiple Myeloma. Diagnostics 2021, 11, 88. [Google Scholar] [CrossRef] [PubMed]
- Lee, T.L.; Chen, T.H.; Kuo, Y.J.; Lan, H.Y.; Yang, M.H.; Chu, P.Y. Tumor-associated tissue eosinophilia promotes angiogenesis and metastasis in head and neck squamous cell carcinoma. Neoplasia 2023, 35, 100855. [Google Scholar] [CrossRef]
- Wang, S.A.; Orazi, A.; Gotlib, J.; Reiter, A.; Tzankov, A.; Hasserjian, R.P.; Arber, D.A.; Tefferi, A. The international consensus classification of eosinophilic disorders and systemic mastocytosis. Am. J. Hematol. 2023, 98, 1286–1306. [Google Scholar] [CrossRef]
- Tsilifis, C.; Freeman, A.F.; Gennery, A.R. STAT3 Hyper-IgE Syndrome-an Update and Unanswered Questions. J. Clin. Immunol. 2021, 41, 864–880. [Google Scholar] [CrossRef]
- Rauscher, C.; Freeman, A. Drug-induced eosinophilia. Allergy Asthma Proc. 2018, 39, 252–256. [Google Scholar] [CrossRef]
- van Haelst Pisani, C.; Kovach, J.S.; Kita, H.; Leiferman, K.M.; Gleich, G.J.; Silver, J.E.; Dennin, R.; Abrams, J.S. Administration of interleukin-2 (IL-2) results in increased plasma concentrations of IL-5 and eosinophilia in patients with cancer. Blood 1991, 78, 1538–1544. [Google Scholar] [CrossRef] [PubMed]
- Pichler, W.J. Delayed drug hypersensitivity reactions. Ann. Intern. Med. 2003, 139, 683–693. [Google Scholar] [CrossRef] [PubMed]
- Romagosa, R.; Kapoor, S.; Sanders, J.; Berman, B. Inpatient adverse cutaneous drug eruptions and eosinophilia. Arch. Dermatol. 2001, 137, 511–512. [Google Scholar]
- Curtis, C.; Ogbogu, P.U. Evaluation and Differential Diagnosis of Persistent Marked Eosinophilia. Immunol. Allergy Clin. N. Am. 2015, 35, 387–402. [Google Scholar] [CrossRef] [PubMed]
- Wei, B.M.; Fox, L.P.; Kaffenberger, B.H.; Korman, A.M.; Micheletti, R.G.; Mostaghimi, A.; Noe, M.H.; Rosenbach, M.; Shinkai, K.; Kwah, J.H.; et al. Drug-induced Hypersensitivity Syndrome/Drug Reaction with Eosinophilia and Systemic Symptoms. Part, I. Epidemiology, Pathogenesis, Clinicopathological Features, and Prognosis. J. Am. Acad. Dermatol. 2023. [Google Scholar] [CrossRef] [PubMed]
- Wei, B.M.; Fox, L.P.; Kaffenberger, B.H.; Korman, A.M.; Micheletti, R.G.; Mostaghimi, A.; Noe, M.H.; Rosenbach, M.; Shinkai, K.; Kwah, J.H.; et al. Drug-induced Hypersensitivity Syndrome/Drug Reaction with Eosinophilia and Systemic Symptoms. Part II. Diagnosis and Management. J. Am. Acad. Dermatol. 2023. [Google Scholar] [CrossRef] [PubMed]
- Cutts, L.; Bakshi, A.; Walsh, M.; Parslew, R.; Eustace, K. Diagnosing Omenn syndrome. Pediatr. Dermatol. 2021, 38, 541–543. [Google Scholar] [CrossRef]
- Villa, A.; Notarangelo, L.D.; Roifman, C.M. Omenn syndrome: Inflammation in leaky severe combined immunodeficiency. J. Allergy Clin. Immunol. 2008, 122, 1082–1086. [Google Scholar] [CrossRef]
- Cheng, J.-N.; Luo, W.; Sun, C.; Jin, Z.; Zeng, X.; Alexander, P.B.; Gong, Z.; Xia, X.; Ding, X.; Xu, S.; et al. Radiation-induced eosinophils improve cytotoxic T lymphocyte recruitment and response to immunotherapy. Sci. Adv. 2021, 7, eabc7609. [Google Scholar] [CrossRef]
- Ghossein, N.A.; Bosworth, J.L.; Stacey, P.; Muggia, F.M.; Krishnaswamy, V. Radiation-related eosinophilia. Correlation with delayed hypersensitivity, lymphocyte count, and survival in patients treated by curative radiotherapy. Radiology 1975, 117, 413–417. [Google Scholar] [CrossRef] [PubMed]
- Marks, L.B.; Bentzen, S.M.; Deasy, J.O.; Kong, F.-M.; Bradley, J.D.; Vogelius, I.S.; El Naqa, I.; Hubbs, J.L.; Lebesque, J.V.; Timmerman, R.D.; et al. Radiation dose-volume effects in the lung. Int. J. Radiat. Oncol. Biol. Phys. 2010, 76 (Suppl. S3), S70–S76. [Google Scholar] [CrossRef] [PubMed]
- Rahi, M.S.; Parekh, J.; Pednekar, P.; Parmar, G.; Abraham, S.; Nasir, S.; Subramaniyam, R.; Jeyashanmugaraja, G.P.; Gunasekaran, K. Radiation-Induced Lung Injury-Current Perspectives and Management. Clin. Pract. 2021, 11, 410–429. [Google Scholar] [CrossRef] [PubMed]
- Hosono, Y.; Sawa, N.; Nakatsubo, S.; Ishijima, M.; Uenami, T.; Kanazu, M.; Akazawa, Y.; Yano, Y.; Mori, M.; Yamaguchi, T.; et al. Radiation Pneumonitis with Eosinophilic Alveolitis in a Lung Cancer Patient. Intern. Med. 2018, 57, 1281–1285. [Google Scholar] [CrossRef]
- Akuthota, P.; Weller, P.F. Eosinophilic pneumonias. Clin. Microbiol. Rev. 2012, 25, 649–660. [Google Scholar] [CrossRef]
- Nakayasu, H.; Shirai, T.; Tanaka, Y.; Saigusa, M. Chronic eosinophilic pneumonia after radiation therapy for squamous cell lung cancer. Respir. Med. Case Rep. 2017, 22, 147–149. [Google Scholar] [CrossRef]
- Marchand, E.; Reynaud-Gaubert, M.; Lauque, D.; Durieu, J.; Tonnel, A.B.; Cordier, J.F. Idiopathic chronic eosinophilic pneumonia. A clinical and follow-up study of 62 cases. The Groupe d’Etudes et de Recherche sur les Maladies “Orphelines” Pulmonaires (GERM“O”P). Medicine 1998, 77, 299–312. [Google Scholar] [CrossRef]

| Body System | Disease Manifestations |
|---|---|
| Integumentary System | Atopic Dermatitis Contact Dermatitis Cutaneous T-Cell Lymphoma Eosinophilic Cellulitis/Dermatitis (Wells’ Syndrome) Episodic Angioedema with Eosinophilia (Gleich’s Syndrome) Bullous Pemphigoid Pemphigus Eosinophilic Pustular Folliculitis Systemic Sclerosis |
| Upper Respiratory System | Allergic Rhinitis Chronic Sinusitis Chronic Rhinosinusitis with Nasal Polyps |
| Lower Respiratory System | Aspirin/NSAID Exacerbated Respiratory Disease Asthma Allergic Bronchopulmonary Aspergillosis Eosinophilic Pneumonia Drug-Induced Eosinophilic Lung Disease Chronic Obstructive Pulmonary Disease Lung Transplantation |
| Cardiovascular System | Eosinophilic Myocarditis Cholesterol Crystal Embolism |
| Gastrointestinal System | Eosinophilic Esophagitis Eosinophilic Gastroenteritis Eosinophilic Gastritis Eosinophilic Colitis Eosinophilic Pancreatitis |
| Endocrine | Adrenal Insufficiency (Addison’s Disease) Withdrawal of Glucocorticoids Hypopituitarism |
| Rheumatologic | Eosinophilic Granulomatosis with Polyangiitis (Churg-Strauss) Immunoglobulin G4 Related Disease Diffuse Fasciitis with eosinophilia Eosinophilic Fasciitis (Shulman Syndrome) Eosinophilia Myalgia Syndrome Eosinophilic Myositis |
| Infectious Processes | Parasitic Infection (roundworm, hookworm, tapeworm, etc.) Mycobacterial Infection Protozoa Infection Fungal Infection Viral Infection (HIV, Human T cell Lymphotrophic Virus type 1) |
| Neoplastic Processes | Myeloid Tumors
Mastocytosis |
| Allergic/Immunologic | Idiopathic Hypereosinophilia Hyper IgE Syndrome (Job Syndrome) Omenn Syndrome Drug Induced Eosinophilia Drug Induced Hypersensitivity Syndrome (formerly Drug Reaction with Eosinophilia and Systemic Symptoms) |
| Other | Radiation Exposure |
Disclaimer/Publisher’s Note: The statements, opinions and data contained in all publications are solely those of the individual author(s) and contributor(s) and not of MDPI and/or the editor(s). MDPI and/or the editor(s) disclaim responsibility for any injury to people or property resulting from any ideas, methods, instructions or products referred to in the content. |
© 2024 by the authors. Licensee MDPI, Basel, Switzerland. This article is an open access article distributed under the terms and conditions of the Creative Commons Attribution (CC BY) license (https://creativecommons.org/licenses/by/4.0/).
Share and Cite
Weaver, M.D.; Glass, B.; Aplanalp, C.; Patel, G.; Mazhil, J.; Wang, I.; Dalia, S. Review of Peripheral Blood Eosinophilia: Workup and Differential Diagnosis. Hemato 2024, 5, 81-108. https://doi.org/10.3390/hemato5010008
Weaver MD, Glass B, Aplanalp C, Patel G, Mazhil J, Wang I, Dalia S. Review of Peripheral Blood Eosinophilia: Workup and Differential Diagnosis. Hemato. 2024; 5(1):81-108. https://doi.org/10.3390/hemato5010008
Chicago/Turabian StyleWeaver, Michael Dennis, Bianca Glass, Chance Aplanalp, Gauri Patel, Jeshrine Mazhil, Isabella Wang, and Samir Dalia. 2024. "Review of Peripheral Blood Eosinophilia: Workup and Differential Diagnosis" Hemato 5, no. 1: 81-108. https://doi.org/10.3390/hemato5010008
APA StyleWeaver, M. D., Glass, B., Aplanalp, C., Patel, G., Mazhil, J., Wang, I., & Dalia, S. (2024). Review of Peripheral Blood Eosinophilia: Workup and Differential Diagnosis. Hemato, 5(1), 81-108. https://doi.org/10.3390/hemato5010008

